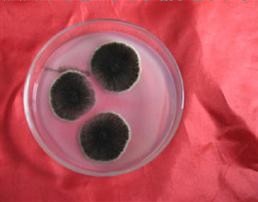

【产品名称】产蛋白酶黑曲霉菌种
【主要成分】黑曲霉菌种 有效活孢子含量≥100亿/克。
【执行标准】复合微生物饲料 GB/T 23181-2008
【菌种特性】黑曲霉,半知菌亚门,丝孢纲,丝孢目,丛梗孢科,曲霉属真菌中的一个常见种。广泛分布于世界各地的粮食、植物性产品和土壤中。在发酵工业主要用于生产淀粉酶、酸性蛋白酶、纤维素酶、果胶酶、葡萄糖氧化酶、柠檬酸、葡糖酸和没食子酸等。有的菌株还可将羟基孕甾酮转化为雄烯。生长适温37℃,最低相对湿度为88%,能引致水分较高的粮食霉变和其他工业器材霉变。在高温、高湿环境下,黑曲霉容易大量生长繁殖产酶生热,侵染棉花时引起落花或烂铃,或生于多汁的果实上,引起腐烂或软腐,侵染洋葱鳞片表面生大量黑粉;梅雨季节亦容易引起衣物发霉等。黑曲霉菌丝直径15~20pm,长约1~3mm,壁厚而光滑。顶部形成球形顶囊,其上全面覆盖一层梗基和一层小梗,小梗上长有成串褐黑色的球状,直径2.5~4.0μm。分生孢子头球状,直径700~800μm,褐黑色。蔓延迅速,初为白色,后变成鲜黄色直至黑色厚绒状,背面无色或中央略带黄褐色。有的菌株还可将羟基孕甾酮转化为雄烯。菌丝呈黑褐色,顶囊大球形,小梗双层,分生孢子为球形,呈黑、黑褐色,平滑或粗糙。对紫外线以及臭氧的耐性强。菌丝发达,多分枝,有多核的多细胞真菌。分生孢子梗由特化了的厚壁而膨大的菌丝细胞(足细胞)上垂直生出;分生孢子
头状如“菊花”。黑曲霉的菌丝、孢子通常呈现各种颜色,如:黑、棕、绿、黄、橙、褐等,菌种不同,颜色也不同。可引起食物、谷物和果蔬的霉腐变质。是制酱、酿酒、制醋的主要菌种。是生产酶制剂(蛋白酶、淀粉酶、果胶酶)的菌种。生产有机酸(如柠檬酸、葡萄糖酸等)。
农业上用作生产糖化饲料的菌种。可用来测定锰、铜、钼、锌等微量元素和作为霉腐试验菌。干酪成熟中污染会使干酪表面变黑、变质,对奶油也会产生变色。
【产品用途】食品工业上用作发酵菌种,如用于食醋生产制曲、麸曲法白酒生产制曲、柠檬酸发酵等,主要是利用此黑曲霉分泌产生淀粉酶、糖化酶、柠檬酸、葡萄糖酸、五倍子酸等的功能;在生物肥料工业上,黑曲霉具有裂解大分子有机物和难溶无机物,便于作物吸收利用,改善土壤结构,增强土壤肥力,提高作物产量的效果。
【用法用量】在生物饲料、生物肥料发酵载体中添加本品时按300-500克/吨。
【注意事项】1、本品为活菌制剂,细菌活性较强,应密闭阴凉避光保存。2、禁止与抗生素、杀虫剂、杀菌剂、消毒剂、强酸强碱类产品混合使用。
【有效日期】3年
【包装规格】1000克/袋×20袋/桶
【贮藏方法】阴凉干燥处密封保存

